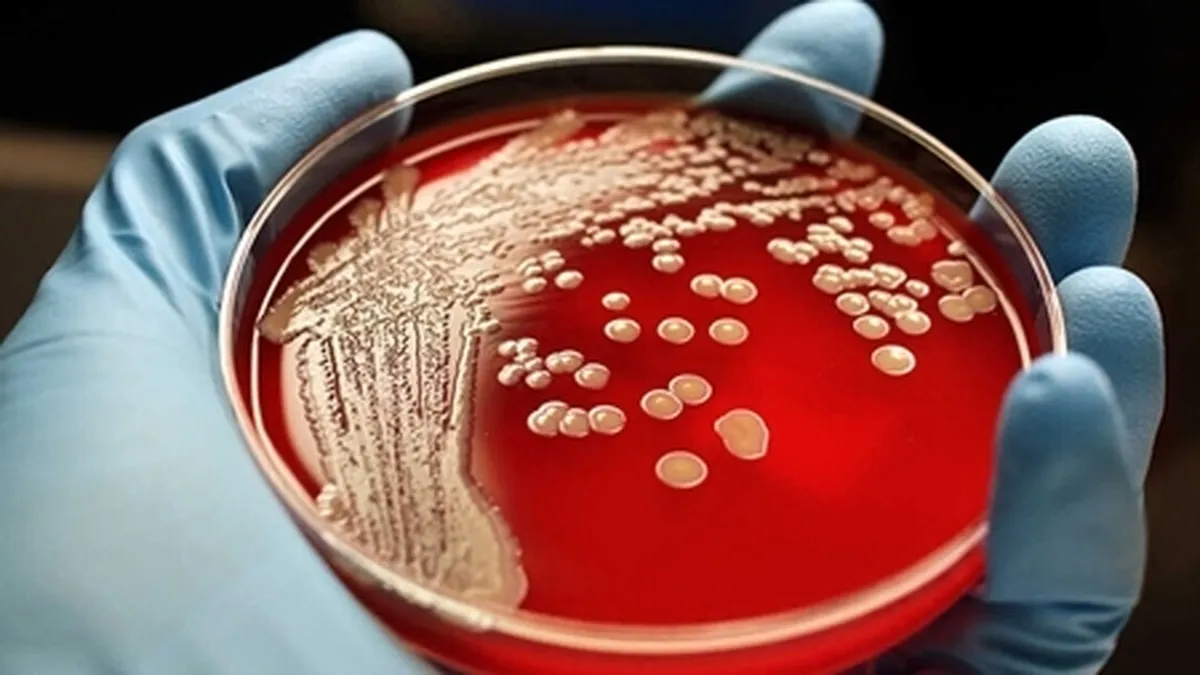

حمایت از طرحهای فناورانه برای جایگزینی مصرف آنتیبیوتیک در حوزه دام و طیور
به گزارش خبرگزاری علم و فناوری آنا، معاونت علمی، فناوری و اقتصاد دانشبنیان ریاست جمهوری با هدف ارتقای مصرف جایگزینهای آنتیبیوتیک در حوزه دام و طیور و تامین نیاز کشور، با همکاری وزارت بهداشت، درمان و آموزش پزشکی و سازمان دامپزشکی اقدام به انتشار فراخوانی برای جذب ظرفیتهای دانشی و تخصصی شرکتهای دانشبنیان کرده است.
در این فراخوان اعلام شده که از طرحهای پیشنهادی شرکتهای دانش بنیان و فناور برای تولید بار اول و تجاریسازی و توسعه بازار مطابق ۶ نیاز فناورانه در اولویت، حمایت خواهد شد.
بر همین اساس تولیدات فناورانه در حوزههای موثر در محرک رشد و سلامت در دام و طیور همچون «پری بیوتیکها»، «اسیدهای ارگانیک»، «آنزیمهای تجزیه کننده پلی ساکارید ها»، «غیرنشاستهای (فیتازه و آنزیمهای سلولیتیک)» و تولیدات سلامت محور مانند «فاژ ترابی»، «پپتیدهای ضدمیکروبی» مورد حمایت قرار میگیرد.
شاخصهای اصلی برای حمایت از طرحها شامل «عمق دانشی در حوزه زیست فناوری با هدف کاهش بار هزینههای درمان در حوزه سلامت»، «عمق دانشی در حوزه زیست فناوری با هدف ارتقا رشد و سلامت دام و طیور»، «برخورداری از TRL قابل قبول»، «برخورداری از بازار صارداتی» و «برخورداری از زیرساخت تولیدی و یا امکان همکاری با شرکتهای دارای خط تولید» میشود.
انتهای پیام/
- هدایای تبلیغاتی
- غذای شرکتی
- تور استانبول
- غذای سازمانی
- خرید کارت پستال
- لوازم یدکی تویوتا قطعات تویوتا
- مشاوره حقوقی
- تبلیغات در گوگل
- بهترین کارگزاری بورس
- ثبت نام آمارکتس
- سایت رسمی خرید فالوور اینستاگرام همراه با تحویل سریع
- یخچال فریزر اسنوا
- گاوصندوق خانگی
- تاریخچه پلاک بیمه دات کام
- ملودی 98
- خرید سرور اختصاصی ایران
- بلیط قطار مشهد
- رزرو بلیط هواپیما
- ال بانک
- آهنگ جدید
- بهترین جراح بینی ترمیمی در تهران
- اهنگ جدید
- خرید قهوه
- اخبار بورس
























